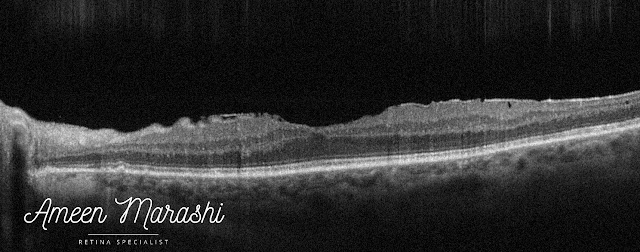

Caused by an epiretinal membrane, clinically, it appears as a sheen abnormal foveal reflex which features epiretinal membrane, due to inflammatory mediators and proliferation of glial cells secondary to a partial separation of posterior cortical vitreous.
![]() |
| Fundus image shows cellophane maculopathy |
OCT features a hyperreflective band covering the inner retinal layers, causing minimal disturbance of inner retinal tissues.
![]() |
| OCT cross-section shows epiretinal membrane |
Cellophane maculopathy itself in individuals with good visual acuity may not need any interventions, but it is warranted to do a detailed peripheral retinal exam to rule out retinal tear or hole
However, an epiretinal membrane may proliferate further and cause additional tangential traction. Thus, it may induce macular pucker or lamellar/pseudo hole and increase disturbance of inner retinal tissues, macular thickness, and reduction of vision.
These patients may require pars plana vitrectomy to remove the epiretinal membrane and some cases, ILM peeling.
Drop a comment below on how would you approach a case of cellophane maculopathy in your clinical practice ??

It is truly well-researched content and excellent wording. I got so engaged in this material that I couldn’t wait to read. I am impressed with your work and skill.pediatric optometrist toledo
ReplyDeleteThank you for your lovely words
DeletePlease visit the Retinal Assistant Module website for clinical-guidelines and courses
https://www.amretina.com
Great information, this information is necessary and essential for everyone. I am thankful to you for providing this kind of good information. https://www.90daymeds.com/
ReplyDeleteI am truly impressed by the details which you have provided regarding..... It is an interesting article for me as well as for others. Thanks for sharing such articles here. cataract surgery bowling green
ReplyDeleteI read all the information you have mentioned in your blog that is really commendable. I really like your post, please share more information with us. korean contact lenses
ReplyDeleteThe information in the post you posted here is useful because it contains some of the best information available. Thanks for sharing about eye doctor mahopac. Keep up the good work.
ReplyDeleteI am very much obliged to you that you have shared retina doctors in houston knowledge with us. I got some different kind of information from your blog and it is really helpful for everyone. Thanks.
ReplyDeleteExcellent post. I really enjoy reading and also appreciate your work.Eye doctor in Westchester This concept is a good way to enhance knowledge. Keep sharing this kind of articles, Thank you.
ReplyDeleteI will share it with my other friends as the information is really very useful. Keep sharing your excellent work. Read more info about dry eye treatment in yorktown
ReplyDeleteGrateful for shaaring this
ReplyDeleteThis was a refreshing blog to read.palmonmac.com
ReplyDeleteThe flow and clarity made a big difference. I genuinely enjoyed the content.
Fugazi Apparel continues to impress with every drop. The quality and style both stand out. It feels like more than just clothing. It represents a lifestyle.
ReplyDelete